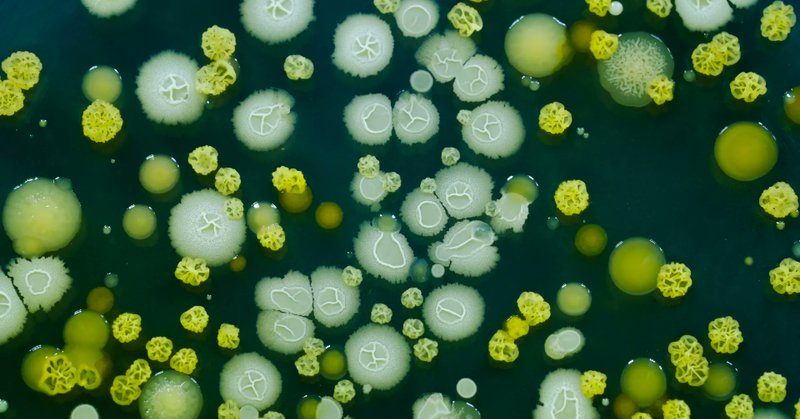

Fabian Januszewski
@drjanosch1
Followers
3K
Following
77K
Media
284
Statuses
24K
Math Prof im Land der Dichter und Querdenker. Bildung & Wissenschaft sind nicht relativierbar. Privat hier. er/he ~~@drjanosch*bsky*social~~
Joined March 2021
@CorneliaBeeking @WDRaktuell Am eigentlichen Problem vorbeizuargumentieren hat sich leider vielerorts als Standard etabliert. Fatal für eine Gesellschaftsform, deren Entscheidungsfindung auf Diskurs basiert. Wer das Problem nicht erkennt, wird es nicht lösen, sondern wird selbst Teil des Problems. 🙈🙉🙊
29
35
232
Jedes Jahr die gleiche scheisse. Leute, wo ist euer Problem mal so eine blöde Maske aufzusetzen?
1K
121
847
Studie: Funktionsstörung des Immunsystems bei einigen Genesenen nach moderat (7%) und schwerem (12%) Covid. Anhaltende Lymphozytopenie - Dysregulation der B-Zellen, CD4+-T-Zellen und Treg-Kompartimente. Link zu LongCovid? https://t.co/QY8BnWVNjH
frontiersin.org
BackgroundLong COVID manifests with heterogeneous clinical outcomes, potentially linked to immune dysfunction. However, the recovery of immune-cell subsets d...
17
63
230
Am Bittersten ist, dass die sich sozial nennende SPD die ganze Sozialstaatszerstörung mitträgt, ohne zumindest einen Preis in Form einer Vermögenssteuer oder einer Reform der Erbschaftssteuer zu verlangen. Eine Partei schafft sich ab.
66
170
901
COVID-19-Welle in England und vielen europäischen Ländern „Wir beobachten derzeit eine deutliche, erhebliche Welle von Covid-Infektionen in ganz England. Die untenstehende Grafik zu den Covid-Krankenhausaufenthalten in England seit September 2023 zeigt dies deutlich. 🧵
25
70
204
Im November 2024 sagte Kanzleramtschef Thorsten Frei (CDU) bei #Lanz, man würde "etwa 30 Milliarden Euro beim Bürgergeld sparen" @_FriedrichMerz gerade im #heutejournal: „Die Summe 30 Milliarden hat niemand gesagt!“ Das Kartenhaus fällt zusammen….
177
1K
6K
Faktencheck Kuban: - Intel (abgesagt, keine Auszahlungen belegt) - Wolfspeed (gestoppt, Zuschüsse nicht ausgezahlt) - ArcelorMittal (kein Geld geflossen) - ACC (seit Juni 2024 pausiert, nicht beerdigt) - Northvolt/Heide (Insolvenz, Übernahme durch Lyten in Arbeit).
110
362
2K
Kann uns jemand helfen? Wir haben einen Link zu einem Interview mit uns. Wenn wir ihn anklicken, wird uns angezeigt, dass dieser Artikeln/Beitrag nicht mehr online sei. Gibt es eine Möglichkeit es trotz dessen noch zitierfähig im Netz zu finden? Bitte DM
2
9
16
Eine von @kahryn_hoffmann initiierte Stellungnahme zur neuen ICD-Codierung für ME/CFS bzw. "Fatigue mit Angabe von PEM". https://t.co/Kt6JsUh9zH
public-health.meduniwien.ac.at
1
46
149
"Die Ständige Impfkommission empfiehlt die Immunisierung für alle Säuglinge vor Beginn der ersten Herbst- und Wintersaison oder direkt nach der Geburt." Durch die Impfung konnte die Inzidenz von RSV-Infektionen um 54% gesenkt werden. #ImpfenSchuetzt
https://t.co/k0xKICp1Zd
br.de
Wenn Säuglinge ins Krankenhaus kommen, dann meist wegen einer RSV-Infektion. Die verursacht teils schwere Atemwegserkrankungen, die in seltenen Fällen sogar tödlich enden können. Seit einem Jahr wird...
10
59
209
Freu mich sehr darauf!
Psychotherapie Netzwerk ME/CFS- heute mit @neurostingl, Wien. #MECFS #PEM #Neurologie #Neuroimmunologie #SFN #OffLabel #Pionier
3
9
123
Weil es da scheinbar aktuell wieder Unsicherheiten gibt: Ja, Viren existieren.
124
66
868
Selbstverständlich arbeitet Christian Lindner weiterhin für Springer und KKR. Das sind eben Unternehmen, die Loyalität und Einsatz für die Firma und ihre (fossilen) Interessen honorieren. Vorbildlich!
5
134
485
1/ Das Kabinett hat heute das Krankenhausanpassungsgesetz beschlossen. Doch was als „Anpassung“ verkauft wird, ist in Wahrheit die Rückabwicklung der Krankenhausreform. Statt für Qualität & Wirtschaftlichkeit, sorgt das Gesetz für Ausnahmen, Schlupflöcher & steigende Kosten.
17
115
348
Schade, dass im deutschen Fernsehen die Wahrheit nur als Komödie gesagt wird. /PM
55
453
2K
Berichte wie dieser zeigen, wie falsch die Behauptung einer flächendeckenden Versorgung von ME/CFS ist, sogar wenn man nur die niedere Hürde des Zugangs zur Primärversorgung gemeint hat. Weil sogar diese Hürde ist für manche Betroffenen strukturell zu hoch.
"Sie kann nicht sprechen, erträgt keine Geräusche, keine Menschen – Milena, 22, hat #MECFS. Ihre Eltern Sabine und Joachim Hermisson kümmern sich seit f��nf Jahren um sie. Hier berichten sie, worauf es in der Pflege ankommt." https://t.co/QRGchOUs4H
2
50
209
Söders Macht in der CSU bröckelt – weniger wegen externer Gegner als wegen innerparteilicher Ermüdung: One-Man-Show, teure Prestigeprojekte, strategische Fixierung auf Aiwanger statt Koalitionsoffenheit, und ein wachsender Generationen- und Strategiekonflikt.
52
204
1K
Die #Impfung und das Tragen von #Masken sind ein effektiver Basisschutz gegen Covid-19 und andere Atemwegserkrankungen.
Schon bevor die ersten Symptome auftreten, kann man bei einer Erkältung andere anstecken. Wann genau die Gefahr am größten ist – und wie lange sie anhält: Hier erfahren Sie es!
2
31
154